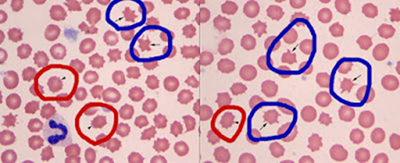

“Spiky Cells”
Created 1 December 2020. Last update 16 January 2021 (Updated to new
format)
What’s in a name?
Some time ago I asked “what’s the difference
between an acanthocyte and an echinocyte anyway”? after having a bit of a
sulk when I was criticized for having commented on one and supposedly having
missed the other.
I typed this into Google,
and found out. “Acanthocytes are irregularly spiculated cells
(spicules are irregular in size, shape and distribution around the RBC
membrane), whereas echinocytes are regularly spiculated cells”.
That’s a bit vague, isn’t it? Let’s have an example.
In this picture acanthocytes are circled in blue and echinocytes in red.
There’s not a lot in the literature on the
matter but one veterinary paper I found (listed below) was enlightening.
Having specified which cell was which, the article went on to say .. “although these could be variants of acanthocytes,
these are echinocytes. This demonstrates that these two RBC shapes can be
difficult to distinguish from each other”.
I’m glad that article said that, as I
don’t think that there’s a really tangible difference here… but clearly others
(who judge me) do.
So.. until I find anything to contradict
this…
Echinocytes are spiky cells (like a hedgehog)
Acanthocytes have much larger protuberances (like an octopus)
Some More Expert Opinion…
An Example from Veterinary practice